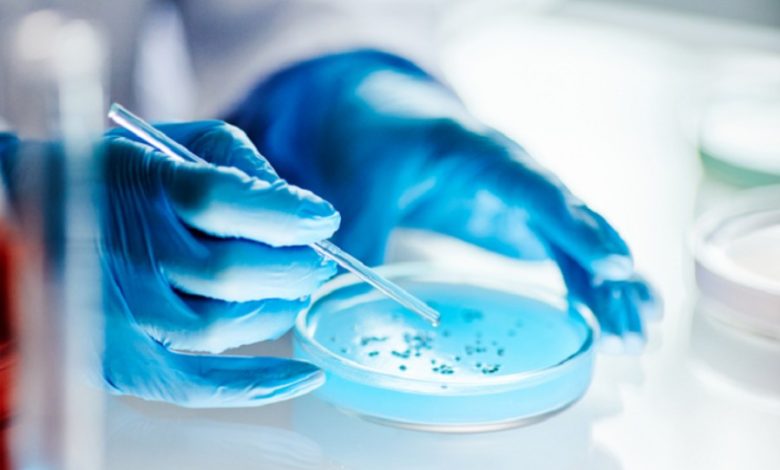

8 أشياء في منزلك قد تحمل جراثيم تهدد صحتك
أبين ميديا/ متابعات
يسلّط عدد من الخبراء الضوء على خطر يهدد صحتنا قد يكمن في الأدوات المنزلية اليومية التي نستخدمها بانتظام.
ورغم حرص الكثيرين على النظافة الشخصية، تظهر الأبحاث أن العديد من الأشياء التي نعتقد أنها آمنة قد تصبح بيئة خصبة لتكاثر الجراثيم والبكتيريا، ما يزيد من خطر الإصابة بعدد من الأمراض.
ويحذّر الدكتور مارتن ثورنتون، كبير المسؤولين الطبيين في “بلو كريست”، من أن “العديد من الأدوات التي نعتبرها مألوفة وغير ضارة، قد تكون مصدرا خفيا للبكتيريا والعفن، وتؤثر على صحتك على المدى البعيد أكثر مما تتوقع”.
وفيما يلي قائمة بـ 8 أشياء في منزلك يجب أن تعيد النظر في طريقة استخدامها وتنظيفها:
– إسفنجة المطبخ
تعد إسفنجة غسيل الأطباق من أكثر الأدوات تلوّثا في المنزل، فقد أظهرت دراسة نشرتها مجلة علم الأحياء الدقيقة التطبيقية، أن كل سنتيمتر مكعب من إسفنجة المطبخ يمكن أن يحتوي على ملايين البكتيريا، مثل الإشريكية القولونية والسالمونيلا والمكورات العنقودية.
النصيحة: استبدل الإسفنجة أسبوعيا، أو استخدم بدائل مثل فرش السيليكون أو مناشف الأطباق القطنية التي يمكن غسلها يوميا.
– زجاجة الماء القابلة لإعادة الاستخدام
يؤكد الدكتور ثورنتون أن زجاجات المياه غير المغسولة يوميا قد تحمل بكتيريا تتسبب في التهابات متكررة بالجهاز الهضمي.
النصيحة: اغسل الزجاجة جيدا بالماء والصابون يوميا، خاصة إذا كنت تستخدمها باستمرار.
– الهاتف المحمول
بات الهاتف امتدادا لأيدينا، نحمله إلى كل مكان، بما في ذلك الحمام. إلا أن دراسات عديدة كشفت أنه قد يحتوي على بكتيريا تفوق ما يوجد على مقعد المرحاض بعشر مرات.
ووجدت كلية لندن للصحة أن 16% من الهواتف المحمولة ملوثة بالإشريكية القولونية، ما يشير إلى سوء نظافة اليدين.
النصيحة: نظّف الهاتف بمطهّر مخصص، وتجنّب استخدامه أثناء الأكل أو في دورات المياه.
– ليفة الاستحمام
تحتفظ الليفة بالرطوبة وتكوّن بيئة خصبة للبكتيريا مثل الزائفة الزنجارية والمكورات العنقودية. وعند استخدامها على جلد متشقق، قد تسبب التهابات جلدية.
النصيحة: غيّر الليفة كل 3 إلى 4 أسابيع، واحرص على تجفيفها جيدا بعد كل استخدام.
– لوحة المفاتيح
كشفت دراسة من جامعة أريزونا أن لوحات المفاتيح قد تحتوي على جراثيم أكثر بـ400 مرة من مقعد المرحاض. ويمكن لبعض أنواع البكتيريا العيش على سطحها ليوم كامل تقريبا.
النصيحة: امسح لوحة المفاتيح بانتظام بمطهّر مصمم خصيصا للإلكترونيات، واغسل يديك قبل وبعد استخدامها.
– حقائب التسوق القابلة لإعادة الاستخدام
رغم كونها خيارا بيئيا ممتازا، إلا أن هذه الحقائب تُهمل غالبا من حيث التنظيف. فاللحوم النيئة أو المواد المجمّدة قد تترك آثارا من البكتيريا داخلها.
النصيحة: خصّص حقائب منفصلة للحوم، واغسلها بانتظام، خاصة بعد الاستخدام.
– أدوات حيوانك الأليف
تقول سيوبان كارول، أخصائية الأعشاب والعلاج الطبيعي، إن ألعاب وفراش الحيوانات الأليفة قد تحتوي على فيروسات وبكتيريا مثل السالمونيلا وداء الكلب والنوروفيروس.
النصيحة: اغسل فراش الحيوان بانتظام، ونظّف فراءه، ولا تسمح له بالصعود إلى سريرك إذا كنت تعاني من ضعف المناعة.
– مناشف الحمام
قد تؤدي المناشف الرطبة إلى تهيج الجلد ومشاكل تنفسية، خاصة لدى المصابين بالربو أو الأكزيما. كما يمكنها أن تنقل فيروسات مثل فيروس كورونا.
النصيحة: اغسل المناشف بعد كل استخدامين إلى 3، واهتم بتجفيفها جيدا، أو استخدم مناشف سريعة الجفاف ومضادة للميكروبات.
المصدر:ذا صن







